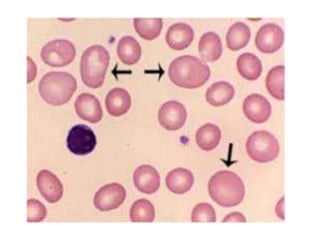
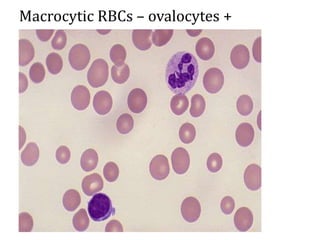
Macrocytic RBCs – ovalocytes +
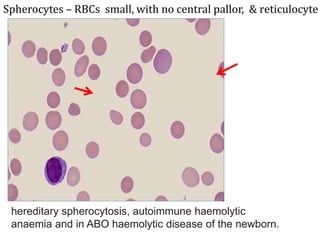
Spherocytes – RBCs small, with no central pallor, & reticulocyte
hereditary spherocytosis, autoimmune haemolytic
anaemia and in ABO haemolytic disease of the newborn.
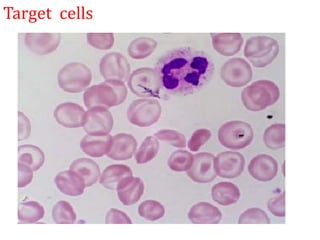
Target cells
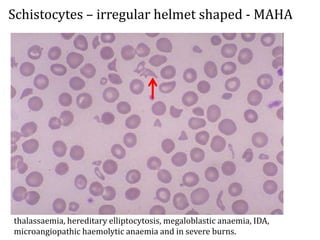
Schistocytes – irregular helmet shaped - MAHA
thalassaemia, hereditary elliptocytosis, megaloblastic anaemia, IDA,
microangiopathic haemolytic anaemia and in severe burns.
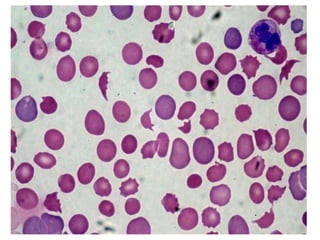
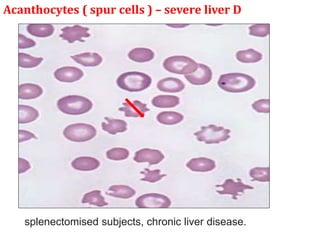
Acanthocytes ( spur cells ) – severe liver D
splenectomised subjects, chronic liver disease.
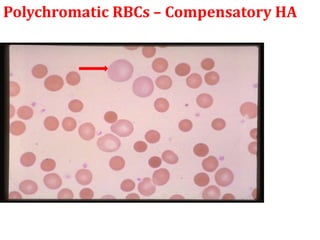
Polychromatic RBCs – Compensatory HA
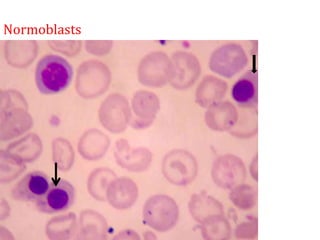
Normoblasts

This document provides an overview of anemia, including its classification, causes, clinical features, laboratory diagnosis, and pathophysiology.
Anemia is defined as a hemoglobin level below the normal range based on age and sex. It can be classified based on red blood cell size (microcytic, normocytic, macrocytic) or pathophysiology (blood loss, impaired RBC production, increased RBC destruction). Common causes include iron deficiency, B12/folate deficiency, blood loss, hemolytic disorders, and bone marrow disorders.
Clinical features depend on the severity and speed of onset of anemia. Laboratory evaluation includes complete blood count, RBC indices, peripheral smear, and additional